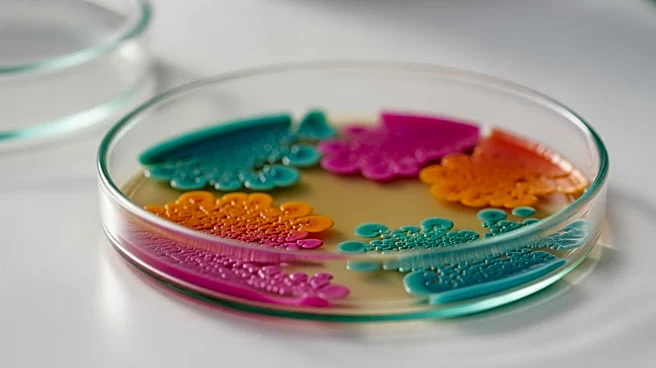
Nursery Attendance Significantly Alters Infant Microbiomes, Study Finds

The San Francisco 49ers had a laundry list of injuries this season. Kyle Shanahan and John Lynch provided a handful of updates during their press conference.
Star pass rusher Nick Bosa is “tracking really good” toward a return for training camp, although there is no official timetable for Bosa’s return.
Rookie Mykel Williams should also return “around the timeline” as Bosa, per John Lynch, who has been impressed with how Williams handled his injury situation:
There’s an ease. There’s a wisdom beyond
the years. He’s tough. He’s got that dark side he can go to on the field. I know he was really upset. You’ve got to be very cognizant of that with these young guys, because they pour into this. It’s really hard on them, and it was really hard on Mykel, but he quickly snapped out of it. But the fact that he’s had Bosa and Fred around to kind of be in his ear and be mentored in a sense of what they go through. The rehab that they go through together has been an awesome deal. He’s a worker. He’s going to work tirelessly.
Lynch reiterated that there is reason to be optimistic about George Kittle’s recovery from an Achilles injury, based on where the tear was: “He’s doing well, he’s already been around the team. George was down for a little bit, but he’s already flipped the switch to recover.”
Lynch believes the chance of surgery and how players are rehabbing after an Achilles injury bodes well for Kittle and his potential impact next season.
Tight end Jake Tonges would hypothetically be out for three weeks with plantar fascia.
Running back Christian McCaffrey had a stinger and checked out OK. Shanahan seemed excited about the prospects of rookie Jordan James moving forward.
Rookie linebacker Nick Martin finally cleared the concussion protocol.
Rookie defensive tackle Alfred Collins might need surgery this offseason after his shoulder went out in the playoff game. Shanahan said he expects Collins back around training camp. That injury and Collins’ recovery may determine what the 49ers do at defensive tackle this offseason.
Jordan Elliott and Yetur Gross-Matos are an unrestriced free agents. Kalia Davis is a restricted free agent. The best pass-rushing defensive tackle will be coming off a serious knee injury, in Mykel Williams.